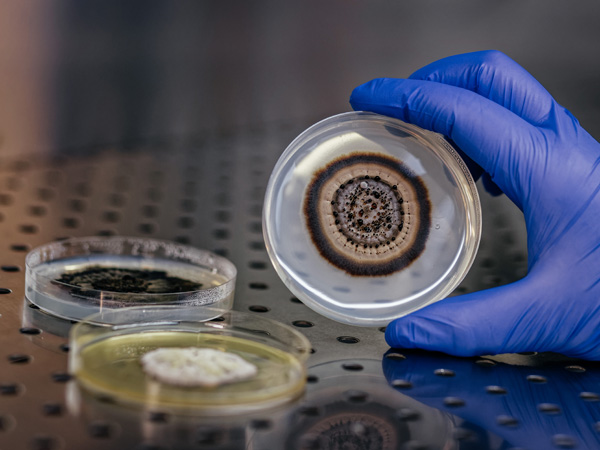

Ministerstwo Nauki i Szkolnictwa Wyższego doceniło naszą działalność na rzecz dokumentowania bioróżnorodności
Pozytywna ocena sposobu zarządzania, organizacji dostępu dla użytkowników oraz stopnia wykorzystania infrastruktury zapewniła Narodowej Kolekcji Bioróżnorodności Organizmów Współczesnych i Kopalnych IB PAN pozycję na liście strategicznych infrastruktur badawczych w Polsce, wśród 14 infrastruktur z nauk biologiczno-medycznych i rolniczych. Ponownie, po pięciu latach, potwierdzona została istotna rola naszego Instytutu jako ośrodka badającego i dokumentującego zmiany różnorodności taksonomicznej, które zachodziły w ciągu milionów lat i jakie są obserwowane obecnie na świecie. Mamy zatem powody do satysfakcji!
Zobacz nasze kolekcje zdigitalizowane w RCIN.
Lista strategicznych infrastruktur badawczych, które pozostały na Polskiej Mapie Infrastruktury Badawczej, dostępna jest na stronie Ministerstwa.

Okazy z kolekcji paleobotanicznej.
Foto: Archiwum NKB IB PAN

Przechowywanie okazów porostów.
Foto: Archiwum NKB IB PAN

Okaz z kolekcji glonów.
Foto: Archiwum NKB IB PAN

Okaz z kolekcji mszaków.
Foto: Archiwum NKB IB PAN

Okaz z kolekcji śluzowców.
Foto: Archiwum NKB IB PAN
Kultury grzybów.
Foto: Archiwum NKB IB PAN

Arkusz zielnikowy z kolekcji roślin naczyniowych.
Foto: Archiwum NKB IB PAN

Arkusz zielnikowy z kolekcji roślin naczyniowych.
Foto: Archiwum NKB IB PAN



